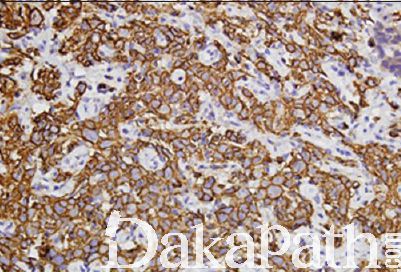

前列腺淋巴瘤
Prostate Lymphomas
概述:
前列腺原发性淋巴瘤是指完全发生于前列腺,无淋巴结、肝、脾累及。
发病部位: 前列腺
诊断要点:
非常少见,占前列腺肿瘤的 0.09%,发病年龄广泛,主要见于 60-70 岁;临床上通常表现为尿路梗阻,类似于前列腺增生;
组织学上,非霍奇金淋巴瘤的几乎所有亚型均可发生;
主要组织学类型有弥漫大 B 细胞淋巴瘤、血管内大 B 细胞淋巴瘤、慢性淋巴细胞白血病/小淋巴细胞淋巴瘤、滤泡性淋巴瘤、套细胞淋巴瘤,结外边缘区淋巴瘤等,NK/T 细胞淋巴瘤非常罕见,形态学与免疫表型与发生其它部位的淋巴瘤相似。
4,前列腺发生的慢性淋巴细胞性白血病/B 小淋巴细胞性淋巴瘤继发性累及较原发性常见。
免疫组织化学染色:
表达相关组织学类型的淋巴瘤标志物
鉴别诊断:
1,慢性非特异性前列腺炎:浸润的淋巴细胞为多克隆性的成熟性淋巴细胞,可混有其他类型的淋巴细胞,呈灶状分布而非弥漫性生长。
2,低分化前列腺腺癌:瘤细胞黏附性较淋巴瘤强,可见顿挫的巢状或腺腔样结构。免疫组化染色表达 PSA 和 P504s 而不表达淋巴细胞标志物可资鉴别。
预后:
1 年肿瘤相关的存活率约 64%,2 年约 50%,5-10 年约 33%,15 年约 16%
治疗:
与其他部位发生的淋巴瘤相似
病例报道:
Primarylymphomasof theprostate: twocasereports and a review of the literature.
参考文献:
Chu PG, Huang Q, Weiss LM.
Am J Surg Pathol. 2005 May;29(5):693-9. Malignant lymphoma involving the prostate: report of 62 cases.
Bostwick DG, Iczkowski KA, Amin MB, Discigil G, Osborne B.
Cancer. 1998 Aug 15;83(4):732-8.